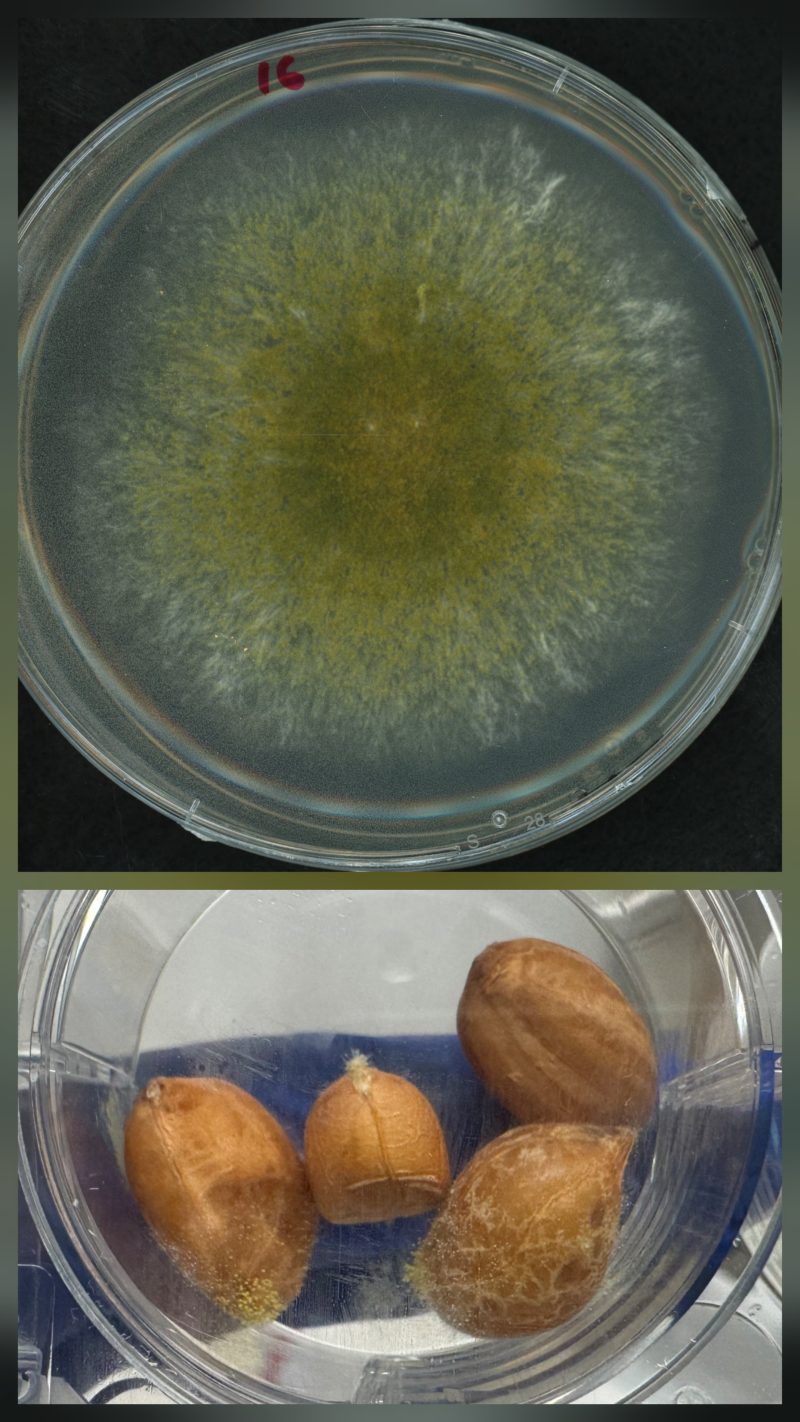

Nicholas Dufault, Barry Tillman, and Marco Goyzueta, UF/IFAS Extension Peanut Team
With the 2025 peanut season concluding, it’s a good time to review this year’s plant disease issues and prepare for the next. Last year, the focus was on soilborne diseases like white mold and CBR (Cylindrocladium Black Rot). However, the late-season narrative for 2025 was dominated by drought stress and its impact on disease management, especially when moisture was absent.
–
Leaf Spots and Rust: Continue to Threaten

Figure 1. A peanut leaf showing symptoms of both late leaf spot (black spots) and rust (orange flecks). Credit: Dr. Nicholas S. Dufault, UF/IFAS.
Late leaf spot (LLS) and peanut rust (Figure 1 right) showed up across many parts of Florida by late August. Mild conditions early in the year were followed by wet periods, created ideal conditions for both diseases to build rapidly. However, many growers saw these diseases slow and/or decrease in intensity with the abnormally dry then drought conditions that started in early September. This led to changing our focus from managing disease to surviving a drought.
However, some key disease management issues to consider in 2025 were:
- Fungicide Strategy: Growers who maintained a consistent spray schedule, about every 14 days or less, generally achieved better control than those who stretched intervals or relied on a single chemical class early in the season. Consistent application timing when the environment is conducive to disease remains one of the strongest strategies for leaf spot and rust management success.
– - Resistance Management: Mixing or rotating FRAC groups remains critical to prevent resistance selection and effectively manage leaf spots. More information on fungicides used for leaf spots management and FRAC classification can be found here.
– - Rust Control: Many fungicides effective against leaf spots also protect against rust. However, timing is everything. Once rust spores establish in the canopy, they can spread quickly and cause rapid defoliation. Growers who saw rust in 2025 should review their fungicide programs with the information available here.
–
Drought Stress: Increased Risk for Aflatoxin
After having relatively good moisture to start, most Florida peanut production areas experienced a prolonged period without significant rainfall, beginning around September 1st. This led to severe drought conditions across Florida, creating a high-risk scenario for aflatoxin issues, particularly in dry-land peanuts.
The dry, hot conditions near harvest favor Aspergillus flavus and A. parasiticus (Figure 2 below), the fungi that produce aflatoxin pod infections. Once infection occurs, prevention is impossible in the field. The 2025 drought made managing aflatoxin virtually impossible in dryland areas.
Figure 2. Top: Aspergillus parasiticus colony exhibiting characteristic greenish-yellow growth on culture medium. Bottom: Peanuts infested with A. flavus, showing typical surface mold growth associated with aflatoxin contamination. Credit: Dr. Marco Goyzueta, UF/IFAS
–
While irrigated fields have a reduced risk due to cooler soil and lower plant stress, any peanuts harvested from dryland corners or non-irrigated fields should be kept separate. A small amount of contaminated dryland peanuts can cause an entire load from an irrigated field to be rejected at the buying point.
To mitigate your aflatoxin risk in 2026, you can use this aflatoxin prediction tool and focus on these prevention and post-harvest steps:
| Management Area | Irrigated Peanuts (Lower Risk) | Dryland/Dry Corners (High Risk) |
| In-Field | Maintain adequate moisture; Protect the canopy. | Reduce stress where possible^; Protect the canopy. |
| Harvest | Harvest as low-risk loads. | Harvest SEPARATELY to prevent contamination of the main crop. |
| Primary Prevention | Timely irrigation (even a single pass) to lower soil temperature and stress. | Segregation at harvest is the single most important action to avoid load rejection. |
^ Note that reduced tillage and heavy cover crops can help reduce water stress. Also, planting earlier (late April) can avoid the typically dryer months of September and October. |
||
–
Key Steps for a Healthier 2026 Crop
A proactive approach is the best defense against unpredictable weather and ever-changing disease threats. Use the following steps to refine your 2026 disease management plan:
- Fungicide Program Review: Commit to rotating chemistries (FRAC groups) and strictly avoid overusing any single product to preserve efficacy.
– - Scout Aggressively: Early detection of disease, especially rust, still offers the biggest opportunity for successful intervention.
– - Optimize Spray Intervals: Avoid stretching spray intervals, especially during optimal disease conditions. Consider shortening the time between applications when weather forecasts indicate conditions highly favorable for disease development (e.g., long wet periods, high humidity) and disease is present.
– - Protect the Foliage: A healthy, intact canopy keeps the soil cooler and minimizes drought and heat stress, directly reducing aflatoxin risk.
– - Plan Around Field History: Rotate fields and, whenever possible, avoid planting peanuts back-to-back in the same field to break disease cycles. Keeps notes when possible on what diseases were present, where they were and what variety was present.
–
Final Thoughts
Every peanut season presents unique challenges, and 2025 strongly reaffirmed that successful disease management requires not only timely intervention but also an understanding of how Mother Nature amplifies or mitigates disease.
As you prepare for 2026, take the time to review your notes, examine your fungicide records, and consult with your local UF/IFAS Extension agent about optimizing your disease management plan.
- 2025 End-of-Season Florida Peanut Disease Notes - October 24, 2025
- Southern Rust Confirmed in the Florida Panhandle – June 2025 - June 6, 2025
- Stay Ahead of Disease with the Spore Report: A New Tool to Assist with Potato and Watermelon Management - April 11, 2025
